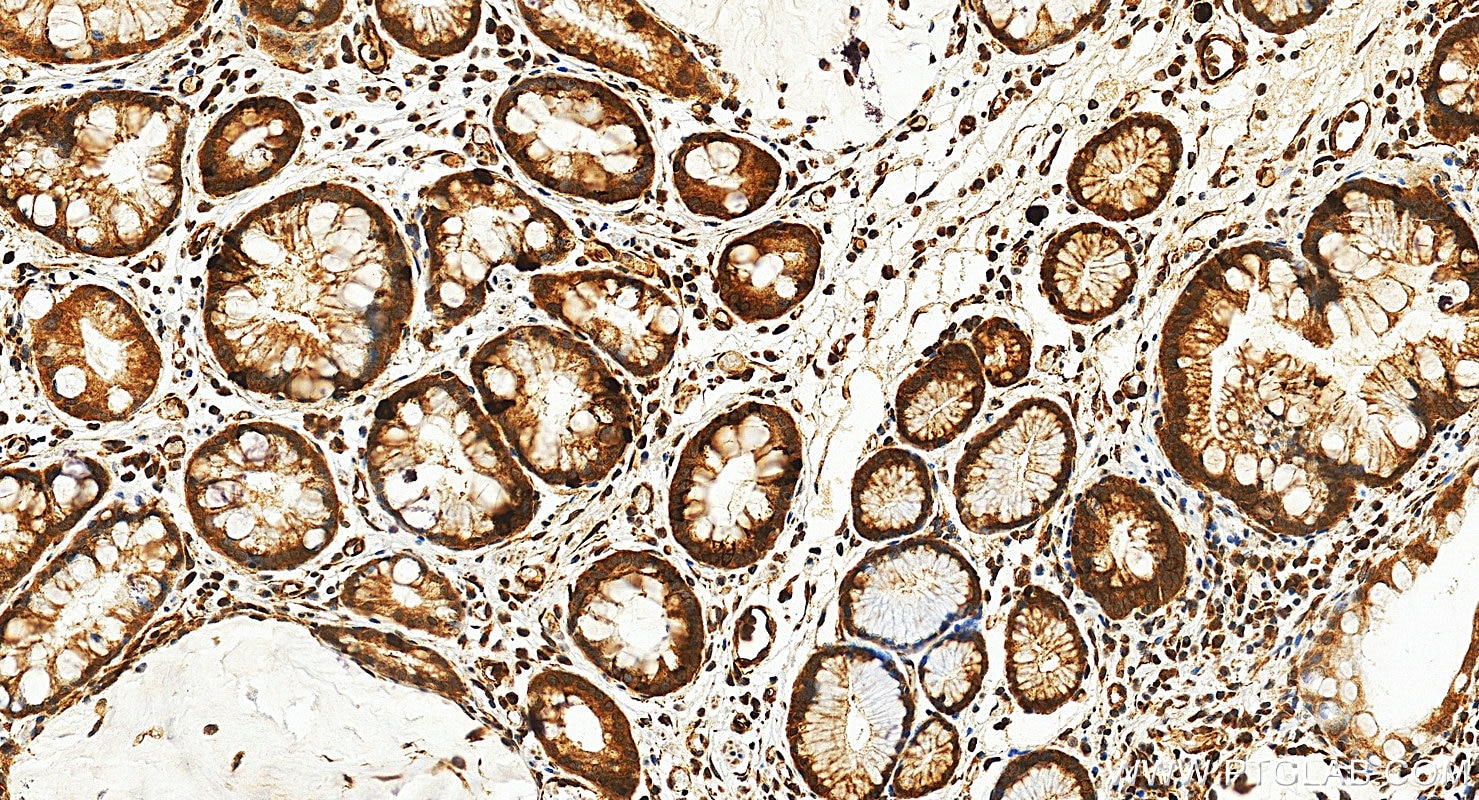
Immunohistochemical analysis of paraffin-embedded human stomach cancer tissue slide using 20960-1-AP (HIF-1 alpha antibody) at dilution of 1:200 (under 20x lens). Heat mediated antigen retrieval with Tris-EDTA buffer (pH 9.0). Immunohistochemistry (IHC) staining of human stomach cancer tissue using HIF-1 alpha Polyclonal antibody (20960-1-AP)
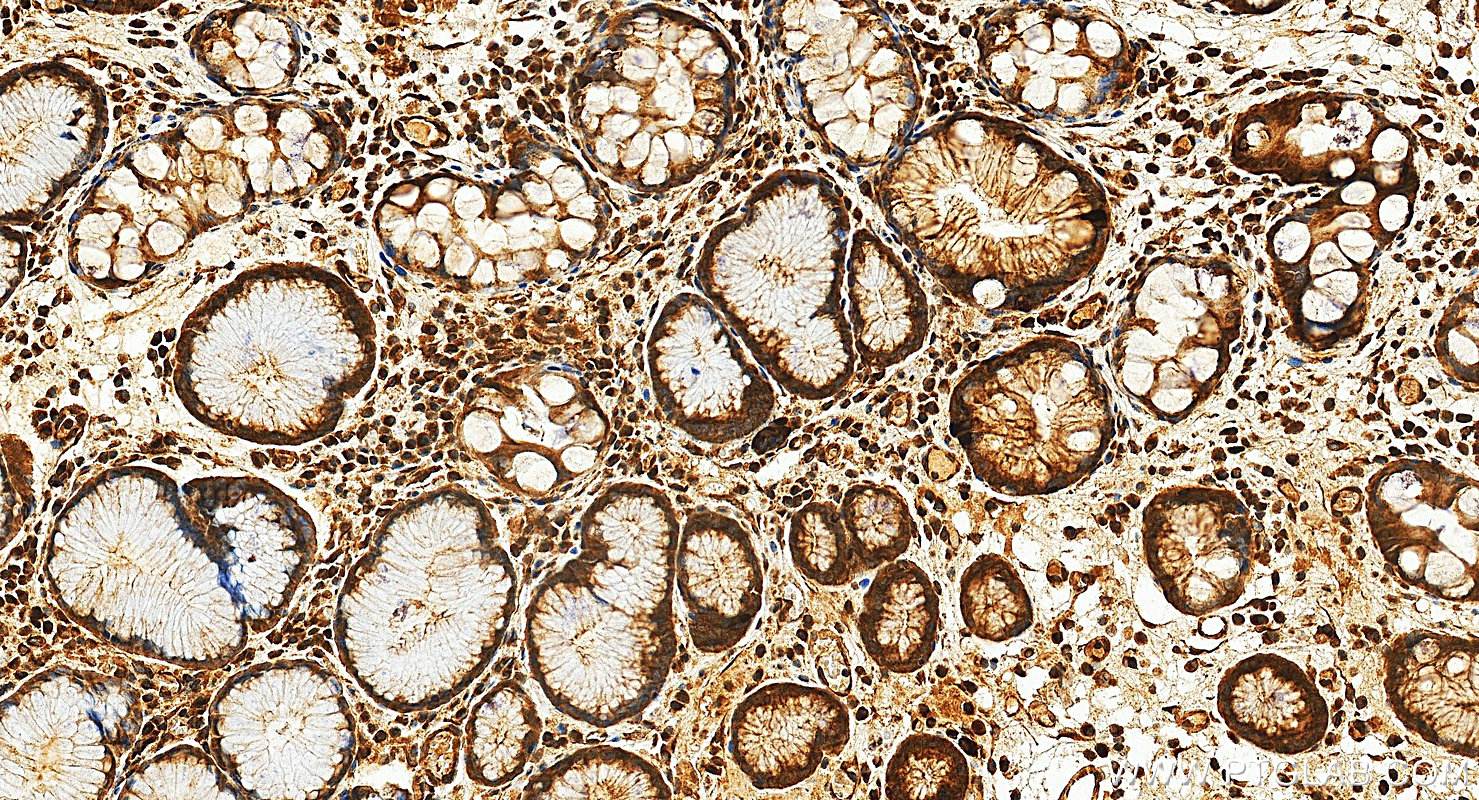
Immunohistochemistry (IHC) staining of human stomach cancer tissue using HIF-1 alpha Polyclonal antibody (20960-1-AP)

Tested Applications
| Positive WB detected in | Cobalt Chloride treated HeLa cells |
| Positive IP detected in | HeLa cells |
| Positive IHC detected in | human thyroid cancer tissue, human kidney tissue, human stomach cancer tissue Note: suggested antigen retrieval with TE buffer pH 9.0; (*) Alternatively, antigen retrieval may be performed with citrate buffer pH 6.0 |
| Positive IF/ICC detected in | Cobalt Chloride treated HeLa cells, Cobalt Chloride treated HepG2 cells |
Samples need to be treated with hypoxia stimulation.
Recommended dilution
| Application | Dilution |
|---|---|
| Western Blot (WB) | WB : 1:2000-1:12000 |
| Immunoprecipitation (IP) | IP : 0.5-4.0 ug for 1.0-3.0 mg of total protein lysate |
| Immunohistochemistry (IHC) | IHC : 1:50-1:500 |
| Immunofluorescence (IF)/ICC | IF/ICC : 1:200-1:800 |
| It is recommended that this reagent should be titrated in each testing system to obtain optimal results. | |
| Sample-dependent, Check data in validation data gallery. | |
Product Information
20960-1-AP targets HIF-1 alpha in WB, IHC, IF/ICC, IP, CoIP, chIP, RIP, ELISA applications and shows reactivity with human samples.
| Tested Reactivity | human |
| Cited Reactivity | human, pig, chicken, goat |
| Host / Isotype | Rabbit / IgG |
| Class | Polyclonal |
| Type | Antibody |
| Immunogen |
CatNo: Ag15198 Product name: Recombinant human HIF1a protein Source: e coli.-derived, PGEX-4T Tag: GST Domain: 574-799 aa of BC012527 Sequence: LRSFDQLSPLESSSASPESASPQSTVTVFQQTQIQEPTANATTTTATTDELKTVTKDRMEDIKILIASPSPTHIHKETTSATSSPYRDTQSRTASPNRAGKGVIEQTEKSHPRSPNVLSVALSQRTTVPEEELNPKILALQNAQRKRKMEHDGSLFQAVGIGTLLQQPDDHAATTSLSWKRVKGCKSSEQNGMEQKTIILIPSDLACRLLGQSMDESGLPQLTSYD Predict reactive species |
| Full Name | hypoxia inducible factor 1, alpha subunit (basic helix-loop-helix transcription factor) |
| Calculated Molecular Weight | 826 aa, 93 kDa |
| Observed Molecular Weight | 120 kDa |
| GenBank Accession Number | BC012527 |
| Gene Symbol | HIF1A |
| Gene ID (NCBI) | 3091 |
| RRID | AB_10732601 |
| Conjugate | Unconjugated |
| Form | Liquid |
| Purification Method | Antigen affinity purification |
| UNIPROT ID | Q16665 |
| Storage Buffer | PBS with 0.02% sodium azide and 50% glycerol, pH 7.3. |
| Storage Conditions | Store at -20°C. Stable for one year after shipment. Aliquoting is unnecessary for -20oC storage. 20ul sizes contain 0.1% BSA. |
Background Information
HIF1a, the major regulator of the cellular responses to hypoxia, consists of an oxygen-sensitive subunit, HIF1 alpha (HIF1A), and an oxygen-insensitive subunit, HIF1 beta (arylhydrocarbon receptor nuclear transporter [ARNT]). Under normal oxygen conditions, HIF1a is continuously produced and destroyed, in a process involving hydroxylation, interaction with von Hippel-Lindau (VHL) protein, polyubiquitylation and subsequent proteasomal degradation. Under hypoxic conditions, hydroxylation is impaired and HIF1a is stabilized. HIF1a localizes in cytoplasm in normoxia, but it can translocate into nuclear in response to hypoxia. The calculated molecular weight of HIF1a is 93 kDa, but the modified protein HIF1a is about 110-120kDa (PMID: 11698256, .PMID: 7539918). .
Protocols
| Product Specific Protocols | |
|---|---|
| IF protocol for HIF-1 alpha antibody 20960-1-AP | Download protocol |
| IHC protocol for HIF-1 alpha antibody 20960-1-AP | Download protocol |
| IP protocol for HIF-1 alpha antibody 20960-1-AP | Download protocol |
| WB protocol for HIF-1 alpha antibody 20960-1-AP | Download protocol |
| Standard Protocols | |
|---|---|
| Click here to view our Standard Protocols |
Publications
| Species | Application | Title |
|---|---|---|
Signal Transduct Target Ther Aberrant Notch-signaling promotes tumor angiogenesis in esophageal squamous-cell carcinoma | ||
Gastroenterology Pancreatic acinar cells-derived sphingosine-1-phosphate contributes to fibrosis of chronic pancreatitis via inducing autophagy and activation of pancreatic stellate cells | ||
Cancer Cell Cancer cell autophagy, reprogrammed macrophages, and remodeled vasculature in glioblastoma triggers tumor immunity | ||
Nat Cell Biol A single-cell transcriptomic landscape of the lungs of patients with COVID-19. | ||
ACS Nano Augmenting Intracellular Cargo Delivery of Extracellular Vesicles in Hypoxic Tissues through Inhibiting Hypoxia-Induced Endocytic Recycling |
Reviews
The reviews below have been submitted by verified Proteintech customers who received an incentive for providing their feedback.
FH royruk (Verified Customer) (12-11-2025) | Good HIF-1α antibody with clean, specific bands and reliable performance in both WB and IF. Solid choice for hypoxia-focused experiments.
|
FH mali (Verified Customer) (12-11-2025) | Reliable HIF-1α antibody that gives clear, specific detection in Western blots and works well in IF/IHC and IP applications, making it a good tool for hypoxia-related studies
|
FH Vignesh (Verified Customer) (09-15-2025) | The results are excellent.
|
FH Carlo (Verified Customer) (01-18-2023) | The quality of the band in western blot is well defined
|
FH Davide (Verified Customer) (09-20-2022) | The image uploaded refers to a hypoxic condition O2<1%. The antibody signal was aspecific and generated aspecific binding in the middle of the organoid.
![]() |
FH Christian (Verified Customer) (01-07-2022) | Unfortunately much background an many unspecific bands in lysates of human chondrocytes and BV2 microclia cells (less unspecific bands in rat chondrocytes).
![]() |
FH Diane (Verified Customer) (02-17-2021) | Separated on a 7.5% SDS PAGE gel, transferred to nitrocellulose membrane. Block with 5% dry milk/PBST at room temperature for one hour. 1:1000 dilution of the primary antibody in blocking solution. Incubated overnight at 4 degrees C on a rocker platform. Secondary antibody 1:1000 secondary (anti rabbit HRP) incubation for two hours at room temperature. Visualization with the Opti-4CN chromogenic substrate kit (BioRad).
![]() |
FH Chun (Verified Customer) (12-05-2019) | A good antibody
|